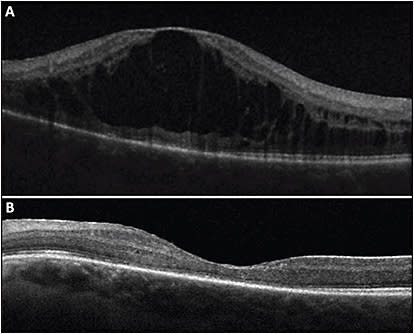
Figure 1. A 29-year-old female with bilateral pars planitis, with recurrent severe macular edema in the left eye (A) which resolved 1 month after starting difluprednate twice daily (B).
COURTESY OF ANGELA BESSETTE, MD.
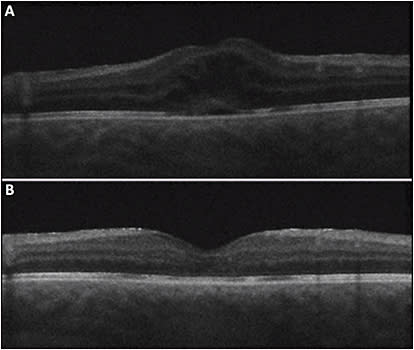
Figure 2. A 9-year-old male with pars planitis and persistent macular edema in the right eye (A) which resolved 4 weeks after subtenon injection of 40 mg triamcinolone (B). 
COURTESY OF AJAY E. KURIYAN, MD, MS.
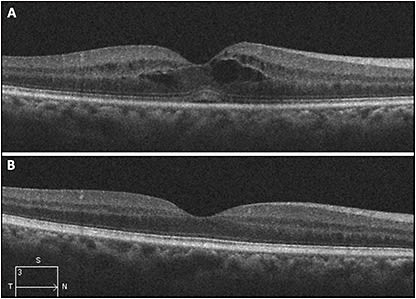
Figure 5. 54-year-old male with bilateral anterior uveitis and underlying ankylosing spondylitis. His anterior chamber inflammation responded to prednisolone acetate; however, he had persistent macular edema (A) which resolved in 1 month with a short course of prednisone starting at 60 mg daily (B).
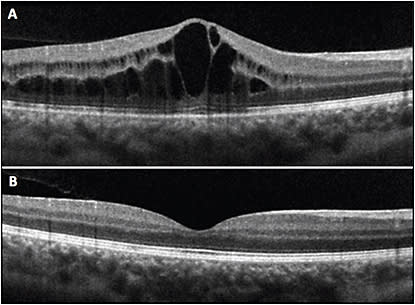
Figure 6. A 16-year-old female with idiopathic panuveitis in both eyes and persistent macular edema in the right eye despite 4 times daily topical difluprednate and 25 mg methotrexate (A). The macular edema resolved 5.5 weeks after starting adalimumab.
COURTESY OF ANGELA BESSETTE, MD.

Macular edema is the most common cause of vision loss in patients with uveitis. It occurs, at least in part, because proinflammatory cytokines alter the permeability of the tight junctions within either the retinal capillary endothelium or the retinal pigment epithelium. Persistent macular edema causes a disruption in the neural networks, and can lead to gliosis and atrophy if untreated, resulting in permanent vision loss. OCT can be used to detect macular edema and follow its response to treatment. Fluorescein angiography (FA) is also useful in identifying the presence and characteristics of macular edema. Treatment options for macular edema associated with uveitis include steroids, systemic steroid-sparing agents, and anti-VEGF agents.
STEROID TREATMENTS
Steroids are the first line of treatment for uveitic inflammation and macular edema because they reduce vascular permeability and inhibit angiogenesis. Within the eye, corticosteroids help maintain the blood-retinal barrier and facilitate reabsorption of fluid exudate. Fluorescein leakage is associated with greater likelihood of improvement in macular edema treated with systemic and intravitreal steroids.1
Topical Steroids
Readily available topical options in the United States include prednisolone acetate and difluprednate (Durezol; Novartis), which is a prednisolone acetate derivative with augmented potency due to fluorination of 2 carbons (Figure 1). In head-to-head studies, difluprednate appears to be efficacious at reducing anterior chamber inflammation at half the dosing frequency of prednisolone acetate.2 Additionally, difluprednate has superior vitreous penetration due to its formulation as a lipid emulsion. In a retrospective study of 35 eyes, difluprednate caused resolution of intraretinal fluid in 40% to 50% of eyes by 2 months, however intraocular pressure (IOP) increased by an average of 6 mmHg.3 In another study, all patients using difluprednate experienced an increase in IOP of at least 5 mmHg and 25% had pressures over 30 mmHg. Notably, many had not previously been considered steroid responders on prednisolone acetate, and this effect seemed to disproportionately affect children.4 Indeed, among pediatric uveitis patients treated with difluprednate, ocular hypertension (OHT) occurs in 50% or more, requiring surgery in 12.5%, and cataract formation occurs in 40%.5
Lynn Hassman, MD PhD, is with the Moran Eye Institute, University of Utah, Salt Lake City, Utah. Angela Bessette, MD, and Ajay E. Kuriyan, MD, MS, are with the Flaum Eye Institute, University of Rochester in New York. Dr. Kuriyan reports consultancy to Allergan; Drs. Hassman and Bessette report no related disclosures.
Periocular Steroid Injection
Triamcinolone is also a fluorinated steroid, with reduced water solubility due to its crystalline formation, which gives it a longer duration of effect. Periocular triamcinolone is most commonly injected into the subtenon space, however it can also be administered subconjunctivally or into the peri- or retrobulbar space. Periocular triamcinolone produces a 75% to 95% reduction in inflammation, however resolution of macular edema only occurs in about 50%, with maximal effect at about 1 month post injection. Relapses occur around 5-6 months post injection, however multiple injections can be given, increasing the rate of resolution of macular edema to up to 78% (Figure 2).6
Ocular hypertension is a potentially serious complication, occurring in about 35%, with surgical intervention required in up to 5%.6,7 Cataract progression also occurs after injection in about 20%, with 14% requiring surgery. These rates for OHT and cataract are somewhat higher than those reported when periocular triamcinolone is used for nonuveitic macular edema, suggesting that uveitis likely plays an additional role in the development of cataract and OHT. Other rare potential complications associated with injection include globe perforation, ptosis, subdermal fat atrophy, extraocular muscle paresis, optic nerve injury, retinal and choroidal vascular occlusion, and cutaneous hypopigmentation.
Intravitreal Steroid Injection
Intravitreal administration of triamcinolone delivers steroid directly to the vitreous and retina, and the crystalline drug is trapped in the vitreous, resulting in resolution of macular edema in up to 80% in one study at a mean of 5 weeks, with recurrences at a mean of 7 months.8 The trade-off, however, is an even higher incidence of ocular complications, with up to 50% of patients developing OHT and 5% requiring filtering surgery within 1 year. Likewise, cataracts progress to requiring surgery in at least 30% of patients within 1 year. Additional complications associated with injection include creation of a PVD and theoretical risk for retinal detachment, as well as endophthalmitis, sterile inflammation, and pseudoendophthalmitis seen when the triamcinolone crystals migrate into the anterior chamber.9
Intravitreal Steroid Implants
Intravitreal corticosteroid implants provide a slow-release source with good bioavailability for treatment of macular edema. Intravitreal dexamethasone (Ozurdex; Allergan) is a biodegradable implant that can be injected in the clinic and releases dexamethasone over 3 months to 6 months. It is FDA approved for posterior uveitis in the United States. In several small prospective studies, this implant was shown to reduce uveitic macular edema in about 70% of patients, with recurrences after 6 months in most, although one-third of eyes remained free of macular edema for a full year.10 It is also efficacious in reducing macular edema in patients with otherwise quiescent uveitis,11 and for preventing recurrence or worsening of macular edema at the time of cataract surgery.12 Reinjection may be required after 5 months to 7 months.
Intravitreal fluocinolone (Iluvien; Alimera Sciences) is a surgically implanted device that releases fluocinolone for 3 years. Data from 2 large cohorts, The Multicenter Uveitis Steroid Treatment Trial (MUST) and Fluocinolone Acetatae Study Group, showed that this implant resulted in resolution of macular edema in 50% of patients by 6 months and an improvement in macular edema in 87% of patients at 2 years, an effect that persisted for 5 years (Figure 3).13,14

The potential benefit of intravitreal fluocinolone, however, must be balanced with the side effects. Ocular hypertension is very common and up to 45% of eyes require incisional glaucoma surgery within 3 years, a 10- to 20-fold increase compared to uveitis patients receiving only systemic treatment. Cataract progression is almost universal, with 90% of phakic eyes requiring surgery (a 3-fold increase compared to the uveitis patients receiving systemic therapy). Both complications primarily occur within the first 2 years.13,14 Finally, there is also a 4.8% incidence of implant dissociation over 6 years, all occurring after 4.8 years as well as rarer surgical complications such as hypotony and endophthalmitis.15 These complications highlight the need for close monitoring of patients after fluocinolone implantation. Bausch + Lomb redesigned the implant to prevent dissociation, however long-term data on the redesigned device is not yet available. Finally, a third intravitreal fluocinolone implant being developed by pSivida (Durasert) is currently being tested in phase 3 trials and may become available soon.
A small comparison chart review between these 2 implants found similar effects on inflammation and vision; however, the dexamethasone effect on macular edema declined by 5 months to 6 months and there was a need for repeat implantation. In contrast, the longer lasting fluocinolone implant was associated with a significantly greater likelihood of cataract progression (100% vs 50%) and need for glaucoma medications and/or surgery, with 7/11 fluocinolone eyes requiring additional IOP lowering therapy, including surgery compared to 0/16 dexamethasone eyes.16
Suprachoroidal Steroids
Recently, a suprachoroidal delivery method of triamcinolone was developed by Clearside Biomedical (Figure 4), in which a 1-mm, 30-gauge needle is used to inject 4 mg triamcinolone in 100 µL into the suprachoroidal space 4 mm posterior to the limbus. In a small pilot study, 7/7 patients with uveitic macular edema experienced some improvement in their edema after just 1 injection, and the improvement in visual acuity (VA) reported was comparable to results obtained with intravitreal triamcinolone as well as the dexamethasone implant.17 Most strikingly, however, there was no associated OHT seen over a 26-week observation period with the suprachoroidal injection. Based on preclinical studies, suprachoroidal injection resulted in 12-fold greater delivery of triamcinolone to the retina and sclera-choroid with only trace amounts in the anterior segment and lens compared to intravitreal injection, which likely accounts for the decreased rates of OHT. Suprachoroidal triamcinolone, therefore, has the potential for as good or better control of posterior inflammation with significantly less risk for cataract and glaucoma development.

Systemic Steroids
Systemic therapy for uveitis is also efficacious in treating uveitic macular edema. Interestingly, the 5-year MUST data showed that, although fluocinolone implantation resulted in better initial control of inflammation, resolution of macular edema was equivalent between the implant and systemic therapy groups by 2 years.13 There was no difference in VA between the 2 groups.13
Systemic steroids effectively control uveitis and many cases of macular edema (Figure 5); however, the systemic side effects, including hypertension, hyperlipidemia, diabetes, osteoporosis, cushingoid fat redistribution, prepubertal growth suppression, poor wound healing, infections, and psychiatric disturbances, limit their use. Systemic corticosteroids are associated with a much lower incidence of OHT and cataract formation compared to periocular or intravitreal steroids. To put it in perspective, the adjusted odds ratio for OHT for patients on systemic prednisone was 1.81, while for patients on just 2 drops of topical corticosteroid per day it was 3.02, and for fluocinolone-implanted eyes it was 29.1.18
SYSTEMIC STEROID-SPARING AGENTS
Systemic immune suppressants present better side-effect profiles and good control of uveitis in many patients. Antimetabolites, including mycophenolate mofetil (Cellcept; Genentech) and methotrexate are commonly used. The 2 therapies were similarly efficacious at treating macular edema in a head-to-head trial, with 50% to 75% of patients experiencing resolution.19
Adalimumab (Humira; AbbVie), a human monoclonal antibody directed against the proinflammatory cytokine tumor necrosis factor (TNF), has recently been FDA approved for treatment of noninfectious posterior, intermediate, and panuveitis in the United States. Systemic treatment reduces the risk of development of macular edema by 67% and induces resolution of macular edema in up to 70% of refractory cases (Figure 6).20 Although not FDA approved, intravitreal adalimumab also improved macular edema in about half of patients in a small group.21 Side effects of the TNF inhibitors include infections, lymphoma, anaphylaxis, and heart and liver failure.
Tocilizumab (Actemra; Genentech), a monoclonal antibody directed against the proinflammatory cytokine IL-6, produced resolution of 8 eyes of 5 patients with refractory uveitic macular edema in a small retrospective study.22 Other biologic immunomodulatory molecules are being explored, including sirolimus, intravenous immunoglobulin, and monoclonal antibodies directed at other anti-inflammatory cytokines, such as L-17.
OTHER TREATMENTS
Only about half of eyes with uveitic macular edema have been shown to fully resolve with corticosteroid treatment, highlighting the multifactorial etiology of uveitic macular edema and the need for alternative therapies. Vascular endothelial growth factor is induced by many proinflammatory cytokines, and not surprisingly, VEGF levels are higher in aqueous samples from uveitic patients compared to healthy subjects.23 Intravitreal injection of ranibizumab (Lucentis; Genentech) has resulted in improvement in uveitic macular edema in several small studies, primarily in cases where inflammation was otherwise controlled and injections were dosed monthly until the edema is controlled and then as needed for recurrence.24,25 While these studies were very small (5 to 6 patients each), the improvement in uveitic macular edema, particularly steroid-refractory edema, makes ranibizumab a very promising adjuvant therapy. Bevacizumab (Avastin; Genentech) has shown similar results early after treatment, but the treatment effect may be more transient.26 Acetazolamide and somatostatin are infrequently used adjunctive therapy options, which may work by reducing RPE leakage.1
SUMMARY
Corticosteroids are effective in many cases of uveitic macular edema. Local therapy is limited by high rates of OHT and cataract formation. Intravitreal fluocinolone in particular carries a very high risk of glaucoma and almost universally causes cataract progression. On the other hand, systemic side effects limit the use of oral steroids. Systemic steroid-sparing therapy, such as antimetabolites or TNF inhibitors, are often required for chronic uveitis. New approaches to steroid delivery, such as suprachoroidal injection, show great promise in the treatment of uveitis, and particularly macular edema because of the potential for targeted delivery with minimal exposure to the anterior segment. Additional approaches, using alternative anti-inflammatory or anti-VEGF drugs are also useful, particularly in cases of steroid-refractory macular edema. RP
REFERENCES
- Fardeau C, Champion E, Massamba N, LeHoang P. Uveitic macular edema. Eye (Lond). 2016;30(10):1277-1292.
- Sheppard JD, Toyos MM, Kempen JH, Kaur P, Foster CS. Difluprednate 0.05% versus prednisolone acetate 1% for endogenous anterior uveitis: a phase III, multicenter, randomized study. Invest Ophthalmol Vis Sci. 2014;55(5):2993-3002.
- Feiler DL, Srivastava SK, Pichi F, Bena J, Lowder CY. Resolution of noninfectious uveitic cystoid macular edema with topical difluprednate. Retina. 2017;37(5):844-850.
- Birnbaum AD, Jiang Y, Tessler HH, Goldstein DA. Elevation of intraocular pressure in patients with uveitis treated with topical difluprednate. Arch Ophthalmol. 2011;129(5):667-668.
- Slabaugh MA, Herlihy E, Ongchin S, van Gelder RN. Efficacy and potential complications of difluprednate use for pediatric uveitis. Am J Ophthalmol. 2012;153(5):932-938.
- Sen HN, Vitale S, Gangaputra SS, et al. Periocular corticosteroid injections in uveitis: effects and complications. Ophthalmology. 2014;121(11):2275-2286.
- Sonmez K, Ozturk F. Complications of intravitreal triamcinolone acetonide for macular edema and predictive factors for intraocular pressure elevation. Int J Ophthalmol. 2012;5(6):719-725.
- Sallam A, Taylor SR, Habot-Wilner Z, et al. Repeat intravitreal triamcinolone acetonide injections in uveitic macular oedema. Acta Ophthalmol. 2012;90(4):e323-e325.
- Tao Y, Jonas JB. Intravitreal triamcinolone. Ophthalmologica. 2011;225(1):1-20.
- Khurana RN, Porco TC. Efficacy and safety of dexamethasone intravitreal implant for persistent uveitic cystoid macular edema. Retina. 2015;35(8):1640-1646.
- Khurana RN, Bansal AS, Chang LK, Palmer JD, Wu C, Wieland MR. Prospective Evaluation of a Sustained-Release Dexamethasone Intravitreal Implant for Cystoid Macular Edema in Quiescent Uveitis. Retina. 2016.
- Larochelle MB, Smith J, Dacey MS. Dexamethasone intravitreal implant in the treatment of uveitic macular edema in the perioperative cataract setting: a case series. Am J Ophthalmol. 2016;166:149-153.
- Multicenter Uveitis Steroid Treatment Trial Research Group, Kempen JH, Altaweel MM, et al. Benefits of systemic anti-inflammatory therapy versus fluocinolone acetonide intraocular implant for intermediate uveitis, posterior uveitis, and panuveitis: fifty-four-month results of the Multicenter Uveitis Steroid Treatment (MUST) trial and follow-up study. Ophthalmology. 2015;122(10):1967-1975.
- Pavesio C, Zierhut M, Bairi K, Comstock TL, Usner DW, Fluocinolone Acetonide Study Group. Evaluation of an intravitreal fluocinolone acetonide implant versus standard systemic therapy in noninfectious posterior uveitis. Ophthalmology. 2010;117(3):567-575.
- Holbrook JT, Sugar EA, Burke AE, et al. Dissociations of the fluocinolone acetonide implant: the Multicenter Uveitis Steroid Treatment (MUST) trial and follow-up study. Am J Ophthalmol. 2016;164:29-36.
- Arcinue CA, Ceron OM, Foster CS. A comparison between the fluocinolone acetonide (Retisert) and dexamethasone (Ozurdex) intravitreal implants in uveitis. J Ocul Pharmacol Ther. 2013;29(5):501-507.
- Goldstein DA, Do D, Noronha G, Kissner JM, Srivastava SK, Nguyen QD. Suprachoroidal corticosteroid administration: a novel route for local treatment of noninfectious uveitis. Transl Vis Sci Technol. 2016;5(6):14.
- Daniel E, Pistilli M, Kothari S, et al. Risk of ocular hypertension in adults with noninfectious uveitis. Ophthalmology. 2017;124(8):1196-1208.
- Rathinam SR, Babu M, Thundikandy R, et al. A randomized clinical trial comparing methotrexate and mycophenolate mofetil for noninfectious uveitis. Ophthalmology. 2014;121(10):1863-1870.
- Diaz-Llopis M, Salom D, Garcia-de-Vicuna C, et al. Treatment of refractory uveitis with adalimumab: a prospective multicenter study of 131 patients. Ophthalmology. 2012;119(8):1575-1581.
- Hamam RN, Barikian AW, Antonios RS, et al. Intravitreal adalimumab in active noninfectious uveitis: a pilot study. Ocul Immunol Inflamm. 2016;24(3):319-326.
- Mesquida M, Molins B, Llorenc V, Sainz de la Maza M, Adan A. Long-term effects of tocilizumab therapy for refractory uveitis-related macular edema. Ophthalmology. 2014;121(12):2380-2386.
- Fine HF, Baffi J, Reed GF, Csaky KG, Nussenblatt RB. Aqueous humor and plasma vascular endothelial growth factor in uveitis-associated cystoid macular edema. Am J Ophthalmol. 2001;132(5):794-796.
- Acharya NR, Hong KC, Lee SM. Ranibizumab for refractory uveitis-related macular edema. Am J Ophthalmol. 2009;148(2):303-309.
- Reddy AK, Cabrera M, Yeh S, Davis JL, Albini TA. Optical coherence tomography-guided ranibizumab injection for cystoid macular edema in well-controlled uveitis: twelve-month outcomes. Retina. 2014;34(12):2431-2438.
- Ghassemi F, Mirak SA, Chams H, et al. Characteristics of macular edema in behcet disease after intravitreal bevacizumab injection. J Ophthalmic Vis Res. 2017;12(1):44-52.








